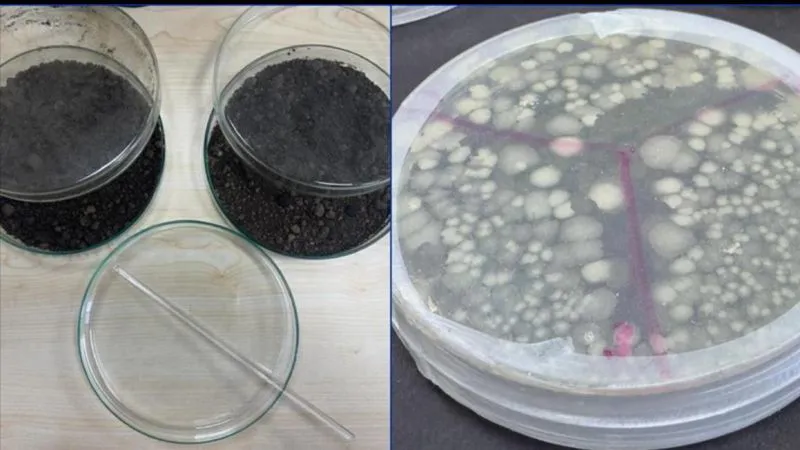

14915,65%1,02
43,12% 0,03
50,34% 0,28
6355,46% 1,68
10168,66% 0,00
Proje kapsamında, doğal ortamlarda yaşayan deniz bakterileri izole edilerek laboratuvar ortamında çoğaltılıyor. Ardından bu bakteriler, petrol ve türevleriyle kirlenmiş topraklara uygulanıyor. Bakteriler, petrolü parçalayarak çevreyi temizliyor ve toprak yapısını iyileştiriyor.
Geleneksel yöntemlerde kullanılan kimyasal temizleyicilere kıyasla, deniz bakterileriyle yapılan biyolojik temizlik hem doğaya zarar vermiyor hem de kalıcı kirliliği önlüyor. Uzmanlar, bu yöntemin uzun vadeli çevre koruma açısından önemli bir adım olduğunu belirtiyor.
İstanbul Üniversitesi tarafından geliştirilen bu yöntem, sadece Türkiye’de değil, petrol kirliliği sorunu yaşayan tüm ülkelerde uygulanabilecek potansiyele sahip. Proje ekibi, bu biyoteknolojik yaklaşımın endüstriyel ölçekte kullanılması için çalışmalarını sürdürüyor.
Projenin hem akademik hem çevresel katkı sunduğuna dikkat çeken yetkililer, teknolojinin yerli ve milli imkânlarla geliştirilmesinin ayrı bir gurur kaynağı olduğunu ifade etti. Bu çalışma, çevre kirliliğiyle mücadelede Türkiye’nin bilimsel kapasitesini de gözler önüne serdi.
Sürdürülebilir Geleceğe Katkı
Deniz bakterileriyle toprak temizliği yöntemi, çevre mühendisliği ve biyoteknoloji alanında sürdürülebilir çözümler arasında öncü uygulamalardan biri olarak öne çıkıyor. İstanbul Üniversitesi’nin bu yeniliği, çevre sağlığı ve doğal kaynakların korunmasında umut vadediyor.
